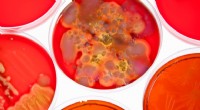
Hvordan bakterier og planteceller deler fælles træk

Af David Chandler
Opdateret 24. marts 2022
Det diploide tal repræsenterer det samlede antal kromosomer, som en organisme bærer i sine somatiske celler - to komplette sæt, et fra hver forælder. Hos mennesker er dette 46 kromosomer.
Kromosomer er lange DNA-strenge foldet til kompakte strukturer. I eukaryoter er de typisk lineære og talrige, som hver bærer tusindvis af gener.
Det haploide tal er kromosomtallet for et enkelt komplet genom. Gameter (sperm og æg) indeholder dette nummer; hos mennesker er det 23.
Mitose er opdelingen af en diploid modercelle i to diploide datterceller, hvilket sikrer, at hver ny celle arver det fulde kromosomkomplement.
Meiose reducerer kromosomtallet til det halve og producerer fire haploide kønsceller fra en diploid modercelle. Denne proces introducerer genetisk variation gennem rekombination.
Når en haploid sædcelle smelter sammen med et haploid æg, er den resulterende zygote diploid, hvilket genopretter organismens fulde kromosomsæt. Hos mennesker indeholder zygoten 46 kromosomer.
Nogle organismer har mere end to sæt kromosomer - polyploidi - som kan give fordele såsom øget kraft eller nye egenskaber. Dette er almindeligt i mange planter.
Varme artikler